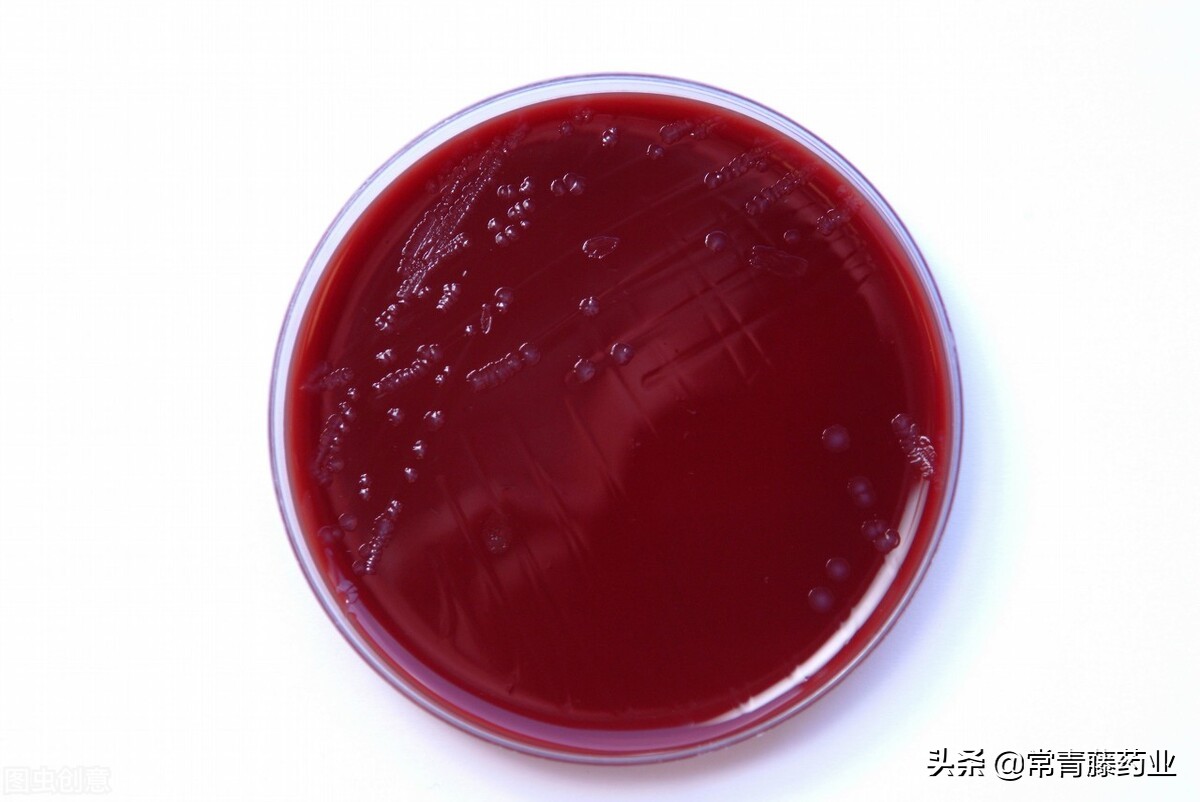
淋病治疗需要注意什么,淋病检查都需要做哪些

上几期都说到了男性、女性感染淋病会有些什么症状以及是怎么传染的,那怀疑自己有淋病了,该检查些什么呢?
检查
涂片检查
淋球菌存在于患有淋病的尿道、宫颈等分泌物中,那医生通常就会使用小棉签或者是小刷子,提取患处的分泌物,经过涂片、染色之后,就可以放到显微镜下观察了。
若这个时候观察到白细胞的数量增加,就说明存在炎症;若观察到白细胞里面有红色的,如咖啡豆样细菌,那就能初步诊断出是感染了淋球菌了。

淋球菌培养
诊断淋病的金标准就是淋球菌培养,把尿道或者是宫颈的分泌物,放进适合淋球菌生长的培养基里,这需要培养1至2天。
若是有淋球菌,这个时候就会有很多的淋球菌了,都能用肉眼观察到具有典型特征的一团团淋球菌了,那这就可以确诊你是感染了淋球菌了。
那患有淋病,要怎么治疗呢?
都知道淋病就是淋球菌的感染,所以要清楚淋球菌的关键,就是需要抗生素治疗,一定要遵循早期、足量且要规则用药的原则。
在治疗的过程中,会根据你的病情变化及时调整你的治疗方案, 常使用到的抗生素有头孢曲松、大观霉素以及头孢噻肟等药物。
这里就要重视一个问题, 就是在使用抗生素期间,一定要记得不要喝酒了,就算是菠萝啤、酒心巧克力等这些都是不可以的,这也是因为抗生素是不可以遇上酒精的,不然就会有生命危险了。
使用药物才一两天,就觉得好了,然后马上停药了?
千万不要这样做,这是在骗你的,不是症状一缓解就是痊愈了,一定不可以这样。在使用抗生素治疗一定要遵医嘱,按疗程用药,不然容易出现耐药性的。
在治疗完全结束后,自身的症状以及体征都全部消失了,还需要赶紧的去一趟医院进行复查,待淋球菌的结果是阴性的,这才是痊愈。
病情还存在,还在使用药物,那可以进行*生活性**吗?
这个也是需要注意的,在治疗还有完全痊愈之前,是严禁有*生活性**,同时你的另一伴也需要进行相应的检查以及治疗,进而彻底的消灭感染源。

那么患有淋病的患者生活会被传染吗?
那还是不用过于担心的,淋球菌在离开我们人体之后的很弱的,很快会死亡,所以日常生活,如吃饭、握手等接触,几乎是不会感染的。
那淋病是不是治愈了,就不会再得了?
你有没有这天真的想法呢?我们人体是不会对淋球菌形成终身免疫的,那这一次的治愈,还会有下一次的感染,
淋球菌的表面有菌毛,我们的免疫系统就是靠着这菌毛来识别淋球菌的,不过这菌毛特别多且容易变异,所以免疫系统也很懵圈的,出现了识别困难,就没有办法很快速的消灭它们,它一有机会,淋病就有了。
#淋病##女性##男性健康##性教育#